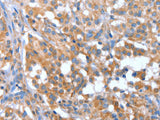
NOD2 Polyclonal Antibody 	Store at -20°C

NOD2 Polyclonal Antibody Store at -20°C
SKU: E-AB-13109-200
NOD2 Polyclonal Antibody Store at -20°C
| SKU # | E-AB-13109 |
| Reactivity | Human |
| Host | Rabbit |
| Applications | IHC |
Product Details
| Isotype | IgG |
| Host | Rabbit |
| Reactivity | Human |
| Applications | IHC |
| Clonality | Polyclonal |
| Immunogen | Synthetic peptide of human NOD2 |
| Abbre | NOD2 |
| Synonyms | ACUG, Arthrocutaneouveal granulomatosis, BLAU, CARD15, CD, CLR16.3, Caspase recruitment domain family, Caspase recruitment domain protein 15, Caspase recruitment domain-containing protein 15, IBD1, Inflammatory bowel disease protein 1, LRR containing prote, member 15 |
| Swissprot | |
| Cellular Localization | Cytoplasm. |
| Concentration | 0.8 mg/mL |
| Buffer | Phosphate buffered solution, pH 7.4, containing 0.05% stabilizer and 50% glycerol. |
| Purification Method | Affinity purification |
| Research Areas | Cancer, Cell Biology |
| Conjugation | Unconjugated |
| Storage | Store at -20°C Valid for 12 months. Avoid freeze / thaw cycles. |
| Shipping | The product is shipped with ice pack, upon receipt, store it immediately at the temperature recommended. |
Related Reagents
| Applications | Recommended Dilution |
| IHC | 1:50-1:200 |
Background
This gene is a member of the Nod1/Apaf-1 family and encodes a protein with two caspase recruitment (CARD) domains and six leucine-rich repeats (LRRs). The protein is primarily expressed in the peripheral blood leukocytes. It plays a role in the immune response to intracellular bacterial lipopolysaccharides (LPS) by recognizing the muramyl dipeptide (MDP) derived from them and activating the NFKB protein. Mutations in this gene have been associated with Crohn disease and Blau syndrome.